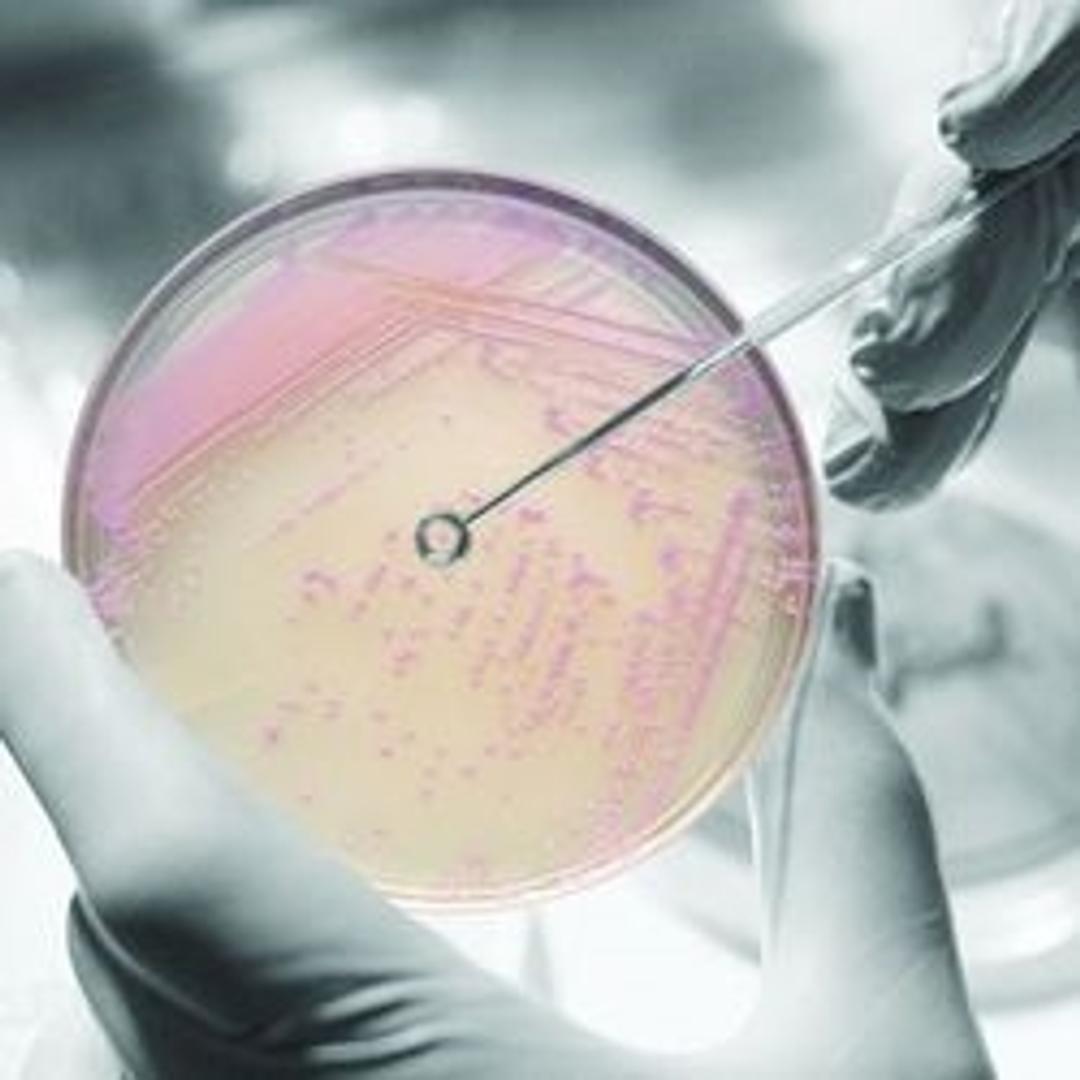

BD BBL™ CHROMagar™ Staph aureus Plate
BD BBL™ CHROMagar™ Staph aureus is a selective medium for the isolation, enumeration, and identification of Staphylococcus aureus from clinical and food sources. The growth of mauve-colored colonies at 24 hours is considered positive for S. aureus for clinical specimens requiring no further confirmatory testing. CHROMagar Staph aureus has been validated by the AOAC™ Research Institute under the Performance Testing Methods for…

The supplier does not provide quotations for this product through SelectScience. You can search for similar products in our Product Directory.
The BBL™ CHROMagar™ family of products utilizes a chromogen mix that consists of artificial substrates (chromogens) that release differently colored compounds upon degradation by specific microbial enzymes, thus assuring the direct differentiation of certain species or the detection of certain groups of organisms with only a minimum of confirmatory tests.
BD BBL™ CHROMagar™ Staph aureus
• Isolate and identify Staphylococcus aureus from clinical sources without the use of confirmatory testing.
• Increase recovery by 11% compared to Mannitol Salt agar.
• Ability to perform susceptibility testing directly from the BBL CHROMagar Staph aureus plate.
• Eliminate the need for a subculture to a nonselective medium—reducing consumable costs and improving workflow.
• Sensitivity 99.5%
• Specificity 99.2%
Note: Not all products are available in all geographies, please contact your local BD representative for product details, specs, or ordering information.